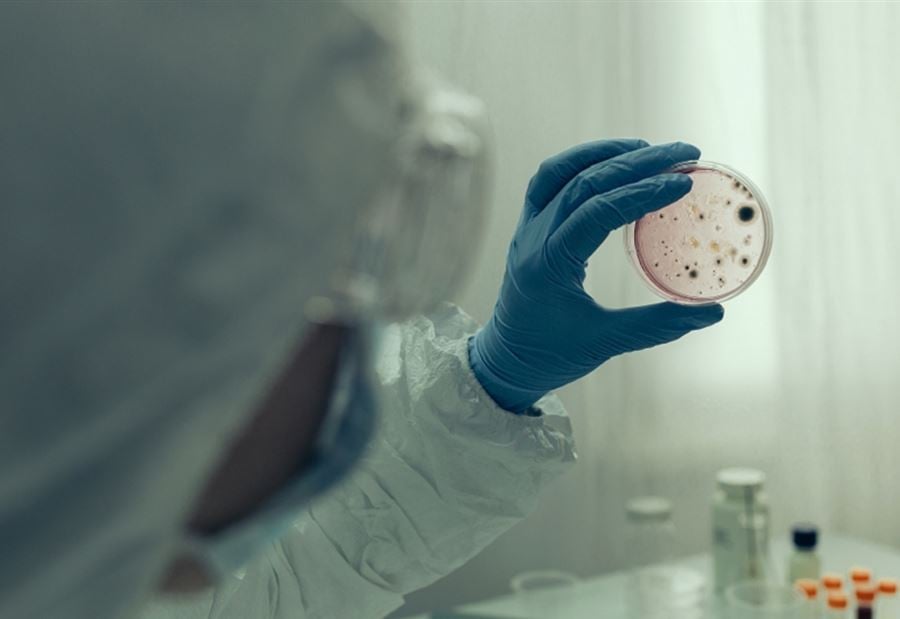

قال محققون من منظمة الصحة العالمية، يبحثون في أصول فيروس كورونا بالصين، إنهم اكتشفوا علامات تدل على أن تفشي الفيروس كان أوسع بكثير في ووهان في كانون الأول 2019 مما كان يعتقد سابقا.
وذكر المحقق الرئيسي لبعثة منظمة الصحة العالمية، بيتر بن امباريك، في مقابلة أجرتها معه شبكة CNN: "كان الفيروس ينتشر على نطاق واسع في ووهان في كانون الأول، وهو اكتشاف جديد".
وأضاف أن البعثة وجدت عدة علامات على انتشار في 2019 على نطاق أوسع، بما في ذلك المنشأ الأول حيث كان هناك أكثر من 12 سلالة من الفيروس في ووهان بالفعل في كانون الأول.
وأتيحت للفريق أيضا فرصة للتحدث إلى أول مريض قال المسؤولون الصينيون إنه أصيب في 8 كانون الأول، وهو عامل مكتب في الأربعينات من العمر، وليس لديه سجل سفر ملحوظ.
وأضاف امباريك، اختصاصي سلامة الأغذية بمنظمة الصحة العالمية، أن العلماء الصينيين قدموا للفريق 174 حالة إصابة بفيروس كورونا في ووهان وحولها في كانون الأول 2019، وهو ما "يعني أن المرض قد أصاب ما يقدر بأكثر من 1000 شخص في ووهان" في ذلك الشهر.
وأشار امباريك إلى أن البعثة، التي ضمت 17 عالما من منظمة الصحة العالمية و17 آخرين من الصين، وسعت من نوع المادة الوراثية للفيروس التي فحصوها من حالات الإصابة المبكرة بفيروس كورونا.
وقال امباريك إن هذا سمح لهم بالنظر إلى عينات جينية جزئية، بدلا من مجرد عينات كاملة. ونتيجة لذلك، تمكنوا من جمع 13 تسلسلا وراثيا مختلفا لفيروس كورونا لأول مرة اعتبارا من كانون الأول 2019. ويمكن أن توفر التسلسلات، إذا تم فحصها مع بيانات المرضى الأوسع في الصين عبر 2019، أدلة قيمة حول الجغرافيا وتوقيت تفشي المرض قبل هذه الفترة.
وقال امباريك: "بعضها من الأسواق... والبعض ليس مرتبطا بالأسواق"، بما في ذلك سوق هوانان للمأكولات البحرية في ووهان، الذي يعتقد أنه لعب دورا في انتشار الفيروس لأول مرة.
وتعتبر التغييرات في التركيب الجيني للفيروس شائعة وغير ضارة في العادة، وتحدث بمرور الوقت مع انتقال المرض وتكاثره بين البشر أو الحيوانات.
ورفض امباريك استخلاص استنتاجات حول ما يمكن أن تعنيه السلالات الـ13 لتاريخ المرض قبل كانون الأول. لكن اكتشاف العديد من المتغيرات المحتملة المختلفة للفيروس قد يشير إلى أنه كان ينتشر لفترة أطول من ذلك الشهر فقط، كما ذكر بعض علماء الفيروسات سابقا أنه من المحتمل أن تكون هذه المادة الوراثية أول دليل مادي يظهر دوليا لدعم مثل هذه الفرضية.
وقال امباريك إن فريق منظمة الصحة العالمية يأمل في العودة إلى ووهان في الأشهر اللاحقة لمواصلة تحقيقاته، رغم أنه لم يتمكن من تقديم مواعيد محددة لرحلة مؤكدة.
ولفت امباريك بأن "هناك حوالي 200 ألف عينة متوفرة مؤمنة الآن ويمكن استخدامها لمجموعة جديدة من الدراسات. سيكون من الرائع لو تمكنا من (العمل) مع ذلك".
وذكر أن بعض عينات الاختبارات البيولوجية الأخرى التي ربما أثبتت فائدتها خلال مهمة ووهان، لم تكن متاحة لهم أيضا، منوها بأنه "تم التخلص من الكثير من العينات بعد بضعة أشهر أو أسابيع، اعتمادا على الغرض من سبب أخذها".
وقال امباريك إن ظروف البعثة، من فترات الحجر الصحي المكثفة والتباعد الاجتماعي، أدت إلى بعض الإحباطات، إلى جانب التدقيق العالمي في سلوكها ونتائجها.
تــابــــع كــل الأخــبـــــار.
إشترك بقناتنا على واتساب

Follow: Lebanon Debate News

الـــمــــزيــــــــــد
الـــمــــزيــــــــــد





